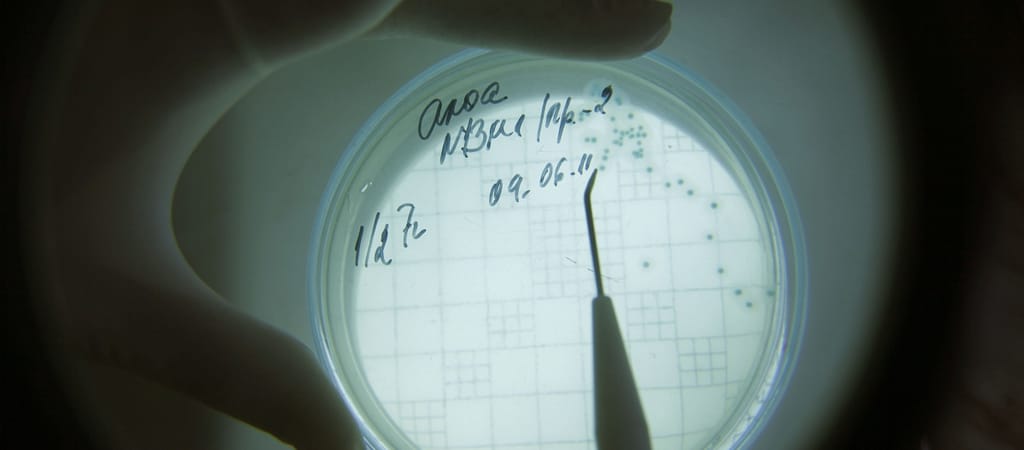

Bár tigrisszúnyogok Magyarországon is vannak, de igen kevesen, így nincsenek meg a feltételei az 1947-ben felfedezett, fejlődési rendellenességet okozó vírus terjedésének.
Magyarországon nincsenek meg a feltételei a Zika-vírus okozta járvány kialakulásának, a vírust terjesztő tigrisszúnyogok rendkívül alacsony számban vannak jelen Magyarországon – mondta Szlávik János, a Szent László Kórház infektológus főorvosa az M1 kedd reggeli műsorában.
A főorvos elmondta: a vírust 1947-ben fedezték fel ugandai majmokban, egy Zika nevű erdőben, majd tíz év elteltével kiderült, hogy a vírus Nigériában emberi megbetegedéseket okozott. Közép-Afrikában évtizedeken keresztül megszokták a betegséget, nagyon sok emberben vannak ellene antitestek, ezért nem okozott különösebb gondot.
Hozzátette: a vírust állítólag egy ázsiai turista hurcolta be Brazíliába a 2014-es futball-világbajnokság idején. A vírus akkor már jelen volt Ázsiában, Thaiföldön, Indonéziában és a Fülöp-szigeteken. 2014-ben indult a járvány, amely gyakorlatilag egész Amerikán végigsöpört, már elérte az Egyesült Államok déli határát – jegyezte meg.
Mint mondta, a Zika vírus okozta mikrokefália, kóros kisfejűség egyébként is előfordul, de Brazíliában két évvel ezelőtt száz eset volt egy évben, tavaly pedig már háromezer, és megállapították, hogy a vírusfertőzés okozta a növekedést.
Gyakorlatilag lehetetlen ellene védekezni
Elmondta azt is, hogy a vírus felnőtteknél olyan tüneteket okoz, mint az influenza: magas láz, izomfájdalom, bevörösödött szem, szemmögötti fájdalom, ízületi fájdalom, néha bőrkiütés jelentkezik, szinte soha nem halálos, és általában egy héten belül magától is elmúlik. A vírus azonban veszélyes a várandós anyákra: a terhesség bármely szakaszában vetélést, halva szülést és kisfejűséget okoz. A főorvos jelezte: ezeknek a csecsemőknek az életkilátásai "szörnyű rosszak", soha nem lesznek teljes értékű felnőttek.

Szlávik János hozzátette: gyakorlatilag lehetetlen védekezni a vírust terjesztő, rendkívül agresszív tigrisszúnyogok ellen, amelyek nem csak napkeltekor és napnyugtakor csípnek, hanem egész nap. Ahol megvannak a szaporodásának a feltételei, gyakorlatilag lehetetlen ellene védekezni – hangsúlyozta, kiemelve ugyanakkor, hogy Magyarországon nem kell tartani ilyen járvány kialakulásától.